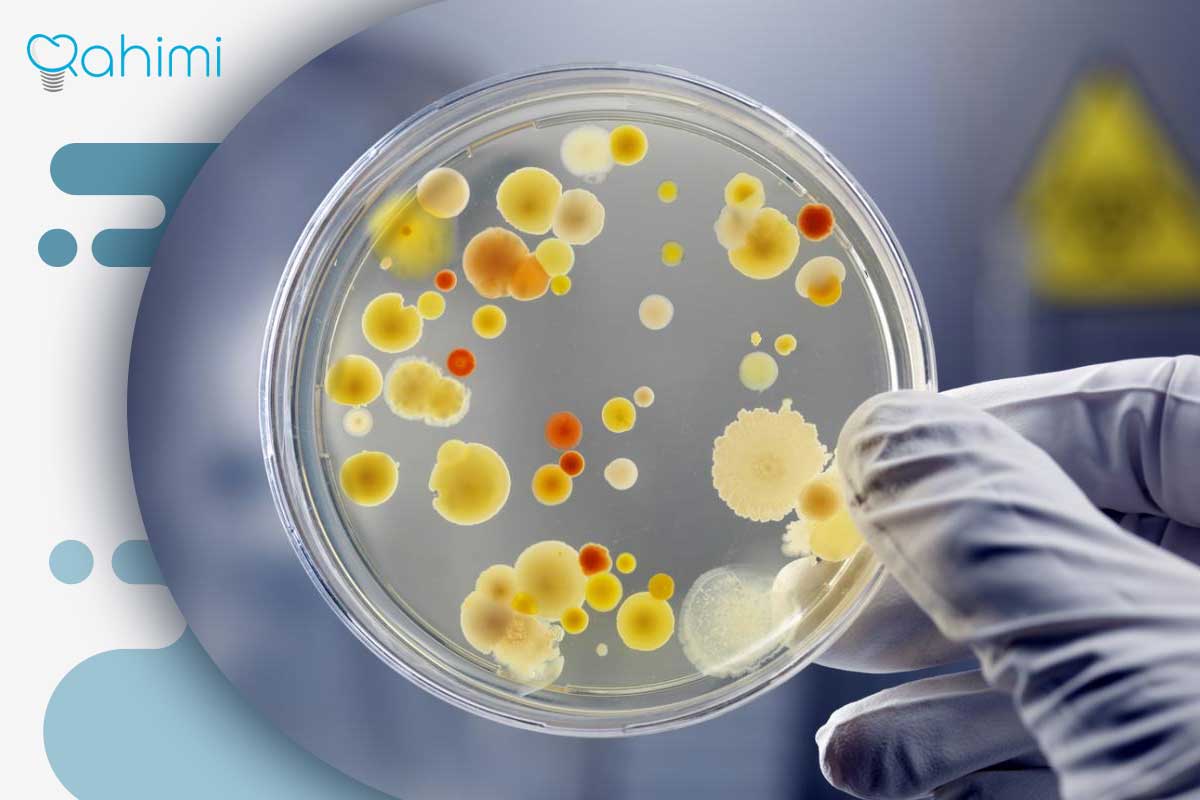
ارتباط بیماری لثه با خطر حمله قلبی: علائم هشدار و راهنمای پیشگیری 1 ورود باکتریها به بدن

بسیاری از ما خونریزی لثه را جدی نمیگیریم و فکر میکنیم فقط یک مشکل موقتی است. اما حقیقت این است که این مشکل کوچک میتواند یک زنگ خطر جدی برای بدن باشد! پژوهشهای علمی نشان میدهند ارتباط تنگاتنگی بین عفونتهای مزمن لثه و افزایش احتمال ابتلا به بیماریهای خطرناک قلبی، از جمله سکته قلبی، وجود دارد. بیماری لثه با خطر حمله قلبی ارتباط مستقیم دارد.
در واقع، باکتریهای دهان میتوانند به راحتی وارد جریان خون شوند و سلامت قلب شما را تهدید کنند. برای آگاهی کامل از این ارتباط و دریافت بهترین مراقبتها، میتوانید به کلینیک دندانپزشکی رحیمی در قم مراجعه کنید.
ارتباط مستقیم: آیا بیماری لثه، خطر حمله قلبی را بالا میبرد؟
پاسخ کوتاه علم امروز بله است. این رابطه فقط یک تصادف نیست، بلکه یک مکانیسم بیولوژیکی مشخص دارد. برای درک بهتر، ابتدا باید بدانیم مشکل لثه چیست و چگونه میتواند از دهان خارج شود:
بیماری لثه چیست و چگونه پیشرفت میکند؟
هنگامی که پلاک دندان (لایه چسبنده باکتریها) برای مدتی روی دندان باقی بماند، لثهها را تحریک میکند. این تحریک باعث ورم و خونریزی میشود که به آن ژنژیویت میگوییم. این مرحله هنوز ساده است و فقط یک علامت هشدار است، اما اگر درمان نشود، کار را برای مرحله بعد سخت میکند.
عفونت عمیق: دروازه ورود باکتریها به بدن
اگر ژنژیویت درمان نشود، عفونت عمیقتر نفوذ کرده و وارد مرحله پریودنتیت میشود. اینجاست که قضیه جدی میشود:
- ایجاد حفره (پاکت): لثه از دندان جدا شده و یک فضای زیر لثه ایجاد میشود که محل تجمع باکتریهای مقاوم است.
- خونریزی مداوم: این عفونت عمیق، باعث میشود لثهها دائماً آسیبپذیر و خونریزیدار باشند.
- ورود به خون: آسیب دائمی لثه باعث میشود دیوارههای آن ضعیف و نازک شوند. این ضعف راه را برای ورود مستقیم باکتریها (و سمومی که تولید میکنند) به جریان خون باز میکند.
وقتی این عوامل به خون میرسند، بدن واکنش نشان میدهد و فرآیندی را آغاز میکند که مستقیماً به سلامت قلب آسیب میزند.
مکانیسم دقیق آسیب به قلب: باکتریها چگونه قلب را تحت تأثیر قرار میدهند؟
ورود باکتریها یا سموم آنها به خون، مانند پرتاب سنگریزههایی کوچک به سیستمی حیاتی است. بدن ما برای دفاع در برابر این مهاجمان، سیستم دفاعی خود (ایمنی) را به کار میاندازد، اما این دفاع گاهی به دوست ما تبدیل به دشمن میشود.
التهاب سیستمی: وقتی دفاع، حمله میشود
باکتریهای دهانی که وارد جریان خون میشوند، به ویژه باکتری پورفیروموناس ژنژیوایلیس (که نام آن را نمیبریم چون تخصصی است)، باعث میشوند بدن مواد شیمیایی خاصی به نام پروتئینهای التهابی آزاد کند. این مواد شیمیایی در تمام بدن پخش میشوند و دو اثر اصلی دارند:
- آسیب مستقیم به دیواره رگها: این التهاب مداوم، دیواره رگهای خونی، بهخصوص رگهای منتهی به قلب، را سست و آسیبپذیر میکند. تصور کنید دیواره شلنگ آب در برابر فشار دیگر تحمل کمتری دارد.
- تشکیل پلاک چربی (آترواسکلروزیس): التهاب باعث میشود کلسترول بد در دیوارههای آسیب دیده رگها راحتتر بچسبد و سخت شود. این فرآیند همان تصلب شرایین است که شریانهای قلب را تنگ میکند. وقتی شریان تنگ میشود، جریان خون به عضله قلب کم شده و خطر حمله قلبی (سکته) به شدت بالا میرود.
قلب سوراخ شده: اندوکاردیت عفونی
در افراد با سوابق مشکلات قلبی (مثلاً دریچههای مصنوعی یا آسیب دیده)، این باکتریها میتوانند مستقیماً روی دریچههای قلب یا دیواره داخلی آن لانه کنند و عفونتی خطرناک به نام اندوکاردیت عفونی ایجاد کنند. این شرایط اورژانسی و بسیار جدی است.
چرا درمان ساده بیماری لثه، محافظ قلب است؟
همانطور که دیدیم، مشکل اصلی، التهاب مزمن ناشی از عفونت است. پس منطق حکم میکند که با رفع منبع عفونت، خطر قلبی نیز کاهش یابد.
خبر خوب این است که ژنژیویت (مرحله اول) با رعایت دقیق بهداشت کاملاً برگشتپذیر است. اگر بتوانیم باکتریها را قبل از ورود به جریان خون حذف کنیم، به قلب فرصت استراحت میدهیم. این کار با دو روش انجام میشود:
- بهداشت روزانه خانگی: مسواک زدن صحیح دو بار در روز و استفاده روزانه از نخ دندان برای از بین بردن پلاکها قبل از سفت شدن ضروری است.
- مراجعه منظم به متخصص: اینجاست که اهمیت متخصص دندانپزشکی در قم و هر شهر دیگری مشخص میشود. جرمها و پلاکهای سختی که با مسواک عادی از بین نمیروند، نیاز به جرمگیری حرفهای دارند.
نقش کلینیک رحیمی در سلامت دهان و قلب شما
در کلینیک دندانپزشکی رحیمی، تمرکز ما فقط زیبایی دندانها نیست. سلامت جامع شما اولویت دارد. در هر جلسه ویزیت، علاوه بر بررسی پوسیدگی، وضعیت لثهها به دقت بررسی میشود. اگر علائمی از التهاب یا پریودنتیت مشاهده شود، با درمانهای پیشرفته و تخصصی، منبع عفونت دهانی ریشهکن میشود تا از ورود باکتریهای خطرناک به سیستم قلبی-عروقی شما جلوگیری شود.
عوارض قلبی دیگر عفونت لثه
علاوه بر حمله قلبی، عفونت لثه میتواند زمینهساز مشکلات دیگری نیز باشد:
- سکته مغزی: التهاب سیستمیک باعث میشود رگهای خونی مغز نیز تحت تاثیر قرار گیرند و احتمال ایجاد لخته و سکته مغزی افزایش یابد.
- فشار خون بالا: برخی مطالعات نشان میدهند که التهاب مزمن میتواند به تنظیم فشار خون نیز کمک نکرده و آن را در سطوح بالاتری نگه دارد.
راهنمای جامع پیشگیری: قلبی امن با دهانی سالم
پیشگیری، کمهزینهترین و مؤثرترین راه برای محافظت از قلب است. با رعایت نکات زیر، میتوانید از سلامت دهان و قلب خود به طور همزمان دفاع کنید:
- مسواک زدن دو بار در روز: این کار باید با تکنیک صحیح انجام شود. هدف فقط ساییدن دندانها نیست. باید نوک مسواک به آرامی زیر خط لثه را نیز پاک کند تا پلاکها فرصت جمع شدن پیدا نکنند.
- نخ دندان، نه یک انتخاب، بلکه یک ضرورت: نخ دندان تنها ابزاری است که میتواند بقایای غذا و پلاک را از بین دو دندان و در مرز لثه خارج کند. اگر لثههای شما خونریزی میکنند، این نشانه نیاز بیشتر به نخ دندان است، نه پرهیز از آن.
- استفاده از دهانشویههای تأییدی: برخی دهانشویهها میتوانند به کاهش بار باکتریایی کمک کنند، اما جایگزین مسواک و نخ دندان نیستند.
- تغذیه دوستدار قلب و لثه: مصرف مواد غذایی سرشار از امگا ۳ (ماهی، گردو) و آنتیاکسیدانها (میوهها و سبزیجات رنگی) به کاهش التهاب در کل بدن کمک میکند. آب فراوان بنوشید تا باکتریها شستشو داده شوند.
علائم هشدار دهنده؛ چه زمانی باید فوراً به متخصص مراجعه کرد؟
اگرچه پیشگیری کلید است، اما دانستن نشانههایی که میگویند عفونت از کنترل خارج شده، بسیار مهم است. تأخیر در مراجعه به متخصص دندانپزشکی در قم میتواند به معنای آسیب جدی به استخوان نگهدارنده دندان و افزایش خطر قلبی باشد.
در صورت مشاهده هر یک از علائم زیر، در اسرع وقت برای ویزیت تخصصی اقدام کنید:
- خونریزی مداوم و غیرطبیعی: خونریزی لثه هنگام مسواک زدن یا نخ دندان کشیدن، اگرچه در ژنژیویت شایع است، اما اگر با رعایت بهداشت روزانه متوقف نشد، زنگ خطر پریودنتیت است.
- بوی بد دهان مزمن (هالیتوزیس): بوی بدی که با مسواک زدن برطرف نمیشود، اغلب نشاندهنده تجمع عفونت و باکتریهای تجزیه کننده در پاکتهای لثهای است.
- عقبنشینی لثه: اگر احساس میکنید دندانهایتان بلندتر شدهاند یا فاصله بین دندانها افزایش یافته است، این یعنی استخوان فک در حال از دست رفتن است.
- لق شدن یا جابجایی دندانها: این علامت نشان میدهد که بافت نگهدارنده دندان به طور جدی آسیب دیده است و نیاز به مداخله فوری برای نجات دندانها وجود دارد.
- ترشحات چرکی: دیدن چرک یا تجمع مایع زرد یا سفید رنگ در اطراف لثه، نشانه عفونت فعال و جدی است.
درمان تخصصی پریودنتیت در کلینیک رحیمی
اگر عفونت از مرحله ژنژیویت عبور کرده و به پریودنتیت رسیده باشد، درمان در خانه کافی نخواهد بود و مداخله حرفهای لازم است. هدف اصلی درمان، پاکسازی کامل محیط عفونی و بستن مجدد پاکتهای لثهای است.
| مرحله / روش درمانی | توضیح | هدف |
|---|---|---|
| ضرورت درمان تخصصی | زمانی که عفونت از ژنژیویت عبور کرده و به پریودنتیت رسیده باشد، درمان خانگی دیگر مؤثر نیست و مداخله حرفهای دندانپزشک ضروری است. | کنترل عفونت پیشرفته و جلوگیری از تخریب بیشتر لثه و استخوان |
| جرمگیری عمیق (Scaling & Root Planing) | مهمترین مرحله درمان پریودنتیت که دقیقتر از جرمگیری معمولی است و معمولاً در چند جلسه با بیحسی موضعی انجام میشود. | حذف کامل منبع عفونت و آمادهسازی لثه برای ترمیم |
| جرمگیری (Scaling) | برداشتن کامل جرمها و باکتریهای زیر خط لثه و روی ریشه دندان توسط دندانپزشک یا متخصص لثه | حذف باکتریها و توقف پیشرفت عفونت |
| صافسازی سطح ریشه (Root Planing) | پس از جرمگیری، سطح ریشه دندان صاف میشود تا محل تجمع مجدد باکتریها از بین برود | کمک به چسبیدن مجدد لثه به دندان و بسته شدن پاکت لثهای |
| آنتیبیوتیک موضعی | قرار دادن مواد آنتیبیوتیکی داخل پاکتهای لثهای باقیمانده برای از بین بردن باکتریهای مقاوم | تقویت اثر درمان و حذف عفونتهای عمیق |
| جراحی لثه (Flap Surgery) | در موارد شدید، لثه بهطور موقت کنار زده میشود تا دسترسی کامل به ریشه و استخوان فراهم شود و پس از پاکسازی، لثه مجدداً فیکس میگردد | کاهش عمق پاکتها، حفظ دندانها و جلوگیری از تحلیل استخوان |
عوامل خطر افزوده؛ چه کسانی باید دو برابر مراقب باشند؟
اگرچه هر فردی با رعایت نکردن بهداشت دهان در معرض خطر است، اما برخی شرایط پزشکی زمینهای، افراد را در برابر التهاب لثه و عفونتهای ناشی از آن بسیار آسیبپذیرتر میکنند و به تبع، خطر عوارض قلبی آنها نیز بالاتر میرود. اگر در دستههای زیر قرار میگیرید، اهمیت مراجعه منظم به کلینیک دندانپزشکی رحیمی قم برای شما دوچندان است:
الف) افراد مبتلا به دیابت (مرض قند)
رابطه بین دیابت و بیماری لثه یک رابطه دوطرفه و بسیار قوی است:
- قند خون بالا = افزایش عفونت: سطح بالای گلوکز در خون، محیطی ایدهآل برای رشد باکتریها در دهان فراهم میکند. همچنین، دیابت توانایی بدن برای مبارزه با عفونت را کاهش میدهد.
- بیماری لثه جدی = کنترل سختتر دیابت: از سوی دیگر، عفونت مزمن لثه (پریودنتیت) باعث التهاب سیستمی میشود که میتواند مقاومت به انسولین را افزایش داده و کنترل قند خون را برای فرد دیابتی بسیار دشوار سازد.
ب) افراد دارای سابقه بیماریهای قلبی و عروقی
کسانی که قبلاً تجربه سکته قلبی داشتهاند، جراحی بایپس انجام دادهاند، یا دریچه مصنوعی دارند، بیشترین ریسک را از نظر عوارض قلبی ناشی از عفونت دهان دارند. برای این گروه، هر گونه عفونت لثه باید به سرعت و با فوریت درمان شود تا خطر اندوکاردیت عفونی به حداقل برسد.
ج) افراد با سیستم ایمنی تضعیف شده: سیستم ایمنی ضعیف، چه ناشی از بیماریهایی مانند HIV، چه مصرف داروهای سرکوب کننده ایمنی (پس از پیوند عضو) یا شیمی درمانی، به فرد اجازه نمیدهد تا به طور مؤثر با باکتریهای دهان مبارزه کند. در نتیجه، عفونتهای لثه سریعتر به مراحل پیشرفته پریودنتیت میرسند.
د) سیگاریها
سیگار کشیدن یکی از بزرگترین عوامل خطر غیرمستقیم برای سلامت لثه است. سیگار کشیدن:
- پنهانکاری علائم: نیکوتین جریان خون به لثهها را کاهش میدهد. این کاهش جریان خون باعث میشود لثه فرد سیگاری برخلاف افراد عادی، کمتر خونریزی کند، حتی اگر عفونت بسیار شدید باشد. این سکوت مرگبار باعث میشود فرد دیرتر متوجه مشکل شود.
- کاهش ترمیم: توانایی بدن برای ترمیم بافتهای آسیب دیده را به شدت کاهش میدهد.
ه) تغییرات هورمونی (بارداری و یائسگی)
تغییرات هورمونی شدید، به ویژه در دوران بارداری (به دلیل افزایش سطح هورمونهای استروژن و پروژسترون)، میتواند باعث واکنشپذیری شدیدتر لثهها نسبت به پلاک شود و به ژنژیویت بارداری منجر شود. این شرایط نیاز به مراقبتهای دقیقتر در طول بارداری دارد.
جمعبندی نهایی
رابطه میان سلامت دهان و قلب، فراتر از یک باور ساده است. این یک حقیقت علمی است که در آن التهاب لثه (پریودنتیت) میتواند با افزایش خطر حملات قلبی ارتباط مستقیم داشته باشد. شناخت عوامل خطر مانند دیابت، سیگار و تغییرات هورمونی، کلید پیشگیری فعال است.
در حالی که پیشگیری روزانه حیاتی است، درمانهای تخصصی مانند جرمگیری عمیق برای مقابله با عفونتهای پیشرفته ضروری است. کلینیک دندانپزشکی رحیمی در قم با ارائه خدمات درمانی پیشرفته، آماده محافظت از سلامت دهان و قلب شماست. همچنین برای تسهیل دسترسی، امکان پرداخت اقساطی دو ماهه نیز فراهم شده است.
پرسشهای متداول ارتباط بیماری لثه با خطر حمله قلبی
خیر. نیکوتین جریان خون را کاهش داده و میتواند خونریزی را پنهان کند، پس عدم خونریزی لثه در فرد سیگاری میتواند نشاندهنده عفونت بسیار پیشرفته باشد.
افراد مبتلا به دیابت کنترل نشده و کسانی که سابقه بیماریهای قلبی عروقی دارند، در معرض بیشترین خطر عوارض مشترک هستند.
بله، با کاهش التهاب مزمن ناشی از عفونت لثه، حساسیت بدن به انسولین بهبود یافته و کنترل دیابت آسانتر میشود.
کلینیک رحیمی در قم با ارائه تسهیلات پرداخت اقساطی دو ماهه، تلاش کرده تا دسترسی به درمانهای تخصصی را برای عموم بیماران آسانتر سازد.